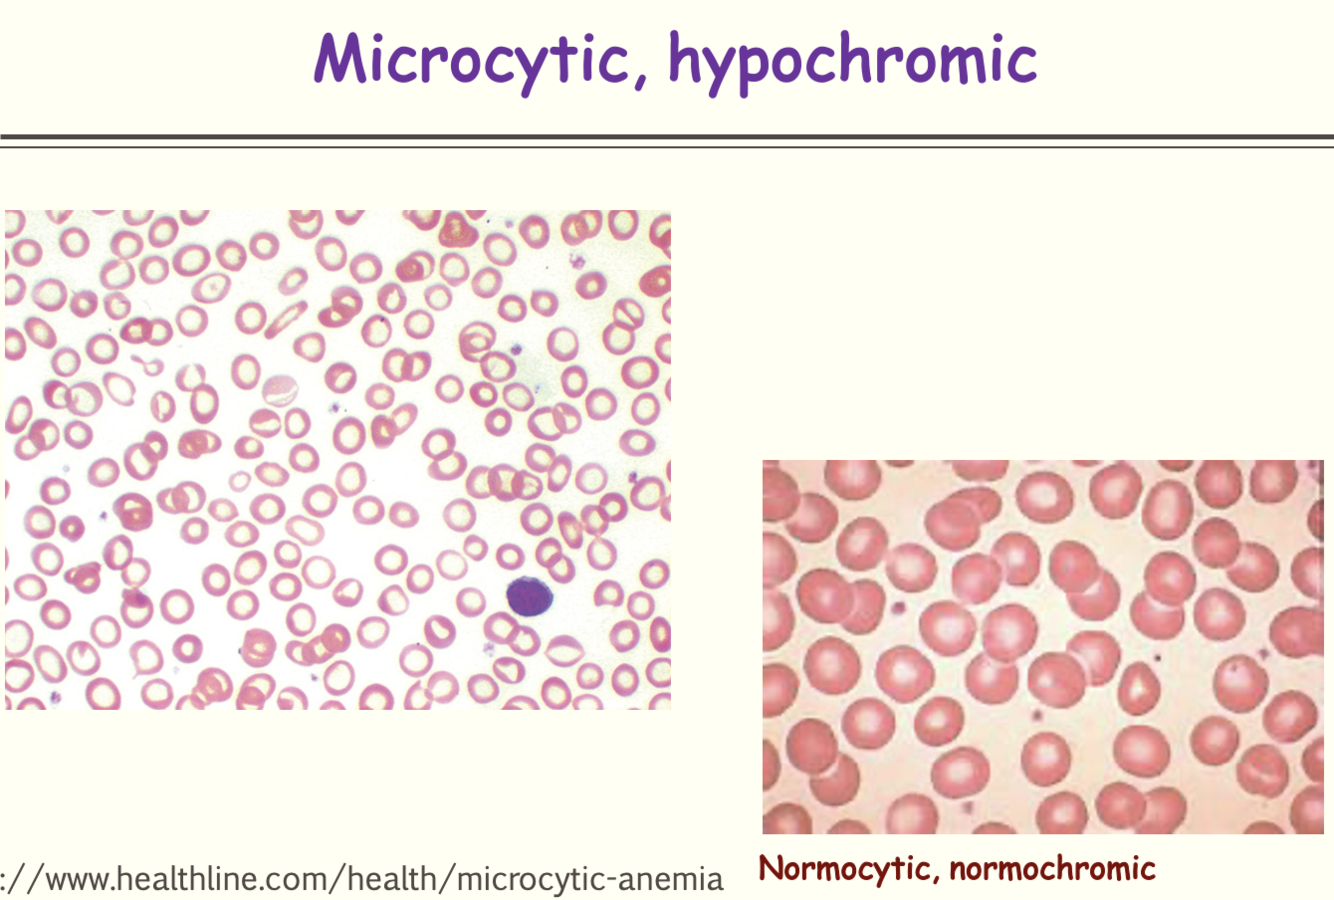
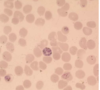

Hemophagocytic lymphohistocytosis (HLH)
macrophages are activated by cytokines or EBV → attack RBCs
(IFN-g, IL-1, IL-2, IL-6, TNF-a)

Major signs and symptoms of hemophagocytic syndrome (HLH)
- Splenomegaly
- Jaundice
- Fever
In HLH, MF will phagocytize ______ (3).
- erythrocytes
- leukocytes
- platelets
In HLH, infections are caused by bacteria, fungi, parasites, viruses. It may also be associated with ____(2).
- Collagen-vascular disease
- Malignancies
HLH will show _____ bone marrow with active _____.
- hypocellular
- hemophagocytosis

If you suspect HVH, what sample would you take at the visit (in office)?
- throat & rectal swabs (viral)
- fungal scrapings
If you suspect HVH, which labs would you order (6)?
- EBV
- CMV
- HIV
- HSV
- CA screen (T cell lymphoma)
- Blood & urine cultures
If you suspect HVH, what tests would you order?
Chest XR for Tb
Which 2 gram negative rods can cause HLH?
- Brucella sp.
- Rickettsia sp.

What characteristics do Brucella sp. share with Rickettsia sp.?
- Gram -
- rods
- aerobic
- intracellular
- both may → HLH
Virulence of brucella sp. is due to ______.
Virulence to rickettsia sp is due to ______.
- O-antigen on LPS
- phospholipase (destroys membrane)
While HLH may be caused by Brucella sp. or Rickettsia sp. which is acquired from unpasteurized milk?
Brucella sp.
(Rickettsia sp. from ticks)

Brucella sp. require on the __________ in order to activate their virulence factor genes
acidic environment of the phagolysosome

Brucella activate virulence factors within the phagolysosome and then move on to the spleen, liver, bone marrow, lymph nodes and kidneys to form _______.
granulomas

______ is the preferred stain for Rickettsia sp.
Geimsa

Rocky Mountain Spotted Fever is endemic to the ______ U.S.
western

Pathological manifestations of Rocky Mountain Spotted Fever are found in the ______.
small blood vessels
(epithelial lining damage → thrombi & vasculitis in skin, lungs, spleen, heart, liver, kidney)

Rocky Mountain Spotted Fever may lead to _____.
DIC
(severe endothelial damage → systemic activation of coagulation cascade)

What labs are ordered if Rocky Mountain Spotted Fever is suspected?
- Pt/PTT
- D-dimer (⇡)
- Fibrinogen (⇣)
- Hct

Epidemic typhus is caused by ______.
Rickettsia prowazekii
Epidemic typhus is transmitted through ______.
louse feces
Epidemic typhus: s/sx
- maculopapular rash
- hypotension, vascular collapse
(HA, fever, splenomegaly)
Anemia: general mechanisms
- ⇣ RBC production
- ⇡ RBC destruction
- Blood loss
MC blood smear presentation for iron deficiency anemia
- hypochromic
- microcytic
(decreased iron or transferrin levels, stores are normal or elevated)